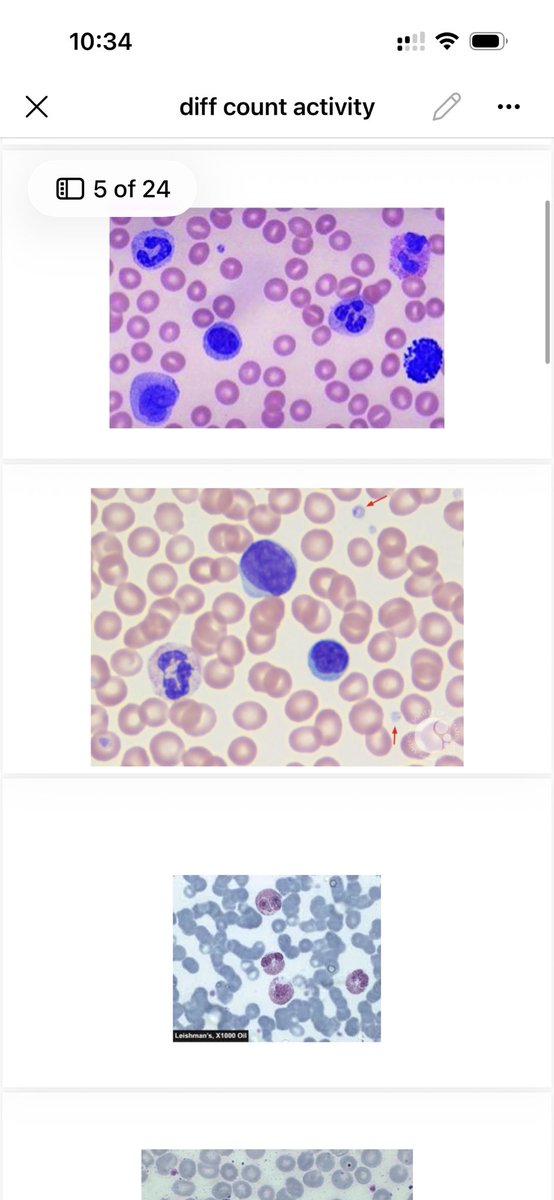
🍃 tweet media

Sabitlenmiş Tweet
DAVE, RMT, MD. COMMISSIONER.
3.6K posts


DAVE, RMT, MD. COMMISSIONER.
@MDCOMMS_
Hello I’m Doc Dave. A Registered Medical Technologist and a Licensed Medical Doctor.
Katılım Ekim 2022
103 Takip Edilen156 Takipçiler

@cl4mantha Hello. Interested. Can do within your budget
English

@avery_blairmei Hello. Interested. Can do it for 300-350
English



@httpstulips_ Interested. RMT, MD here. Send me a dm. Can work within your budget
English

@secretclient_ Hello interested. RMT,MD here. Kindly send me a dm so we can negotiate
English

@mandeukieeee1 Hello interested. RMT,MD here. Kindly send me a dm
English